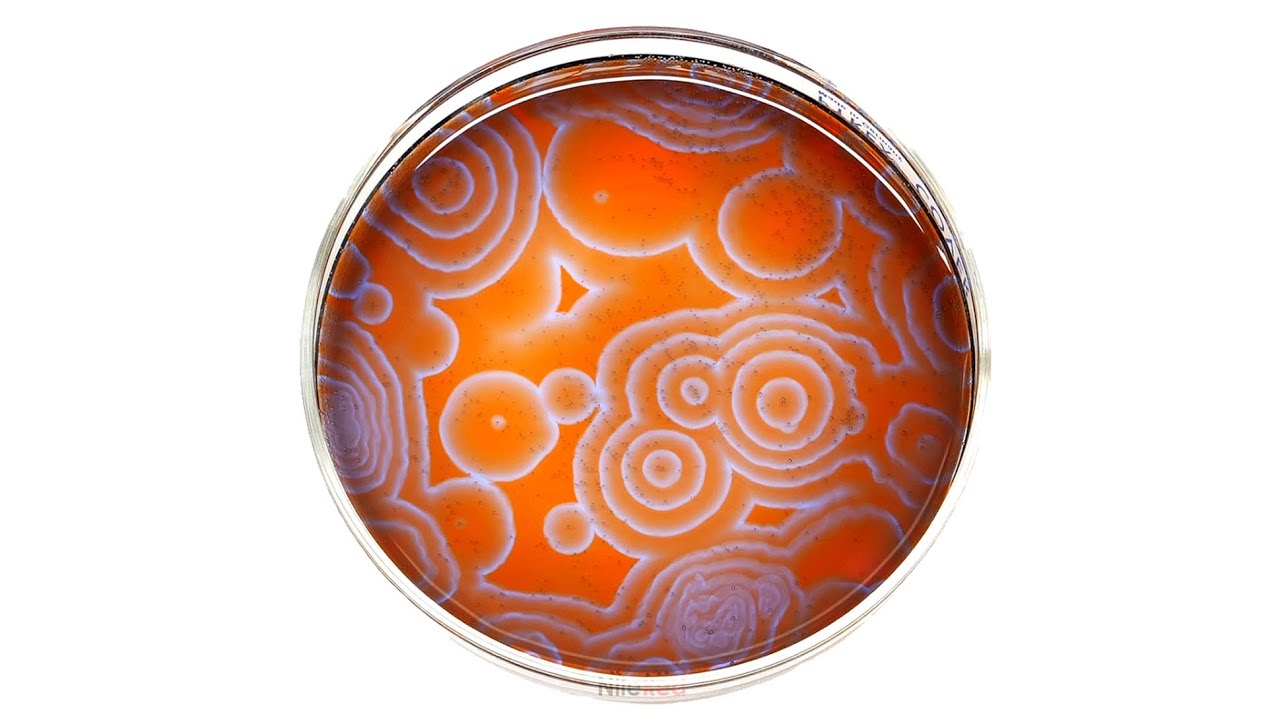

משחזר את אחת התגובות המוזרות ביותר
דרג סרטון זה
התחבר כדי לדרג
תיאור
■ Take this reaction home by pre-ordering the BZ reaction kit! - https://inqfactory.com/nilered
**Reuploaded because I used a clip of BBC footage in the intro and it was automatically flagged by the system and demonetized.
*At the 5min mark, I say 1.5g phenanthroline monohydrate, but 5g is written. It is indeed 1.5g though.
About a year ago, I saw one of the weirdest reactions that I've ever seen. It was called the Belousov-Zhabotinsky reaction, and it's one of the few good examples of an oscillating chemical reaction. I decided to try and do it myself, and this video summarizes the process that I used.
References:
• Intro footage: https://youtu.be/PpyKSRo8Iec
• Mechanism reference: https://goo.gl/iiHPsK
• Procedure taken from: https://goo.gl/tVkEMv
I have also covered another type of oscillating reaction: https://youtu.be/SCoLMfplVWs
-------------------------------------------------------------------------------
Merch - https://nilered.tv/store
-------------------------------------------------------------------------------
Join the community:
Patreon - https://www.patreon.com/nilered
Discord - https://discord.com/invite/3BT6UHf
NileRed Newsletter - https://nile.red/home#newsletter
You can also find me here:
Facebook - https://m.facebook.com/NileRed2
Instagram - https://m.instagram.com/nile.red
Twitter - https://mobile.twitter.com/NileRed2
Nile talks about lab safety: https://youtu.be/ftACSEJ6DZA
Music in credits (Walker by SORRYSINES): https://soundcloud.com/sorrysines/walker